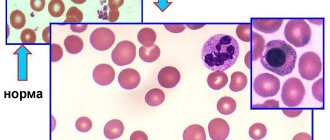

Формы синдрома Гудпасчера
По скорости развития симптомов выделяют две формы заболевания:
- бурное прогрессирование: преобладает почечная и легочная симптоматика;
- летальный исход наступает спустя 11–12 месяцев в результате легочного кровотечения или почечной недостаточности.
- периоды прогрессирования чередуются с периодами полного отсутствия симптомов;
Методы лечения заболевания
При синдроме Гудпасчера развивается воспаление почечных и легочных капилляров иммунного генеза, следствием которого является гломерулонефрит и геморрагический пневмонит. Заболевание названо в честь американского ученого-патофизиолога, впервые описавшего его чуть более ста лет назад. Данный синдром диагностируется преимущественно у мужчин, с частотой примерно 1:1000000. Отсутствие своевременного лечения связано с крайне негативным прогнозом и смертностью большей части больных.
Причины возникновения заболевания точно не выяснены, однако замечена его связь с вирусными патологиями, в том числе, гриппом и гепатитом А, длительным приемом некоторых лекарственных препаратов, вдыханием паров бензина и лаков, курением. Отмечается также наследственная предрасположенность. Влияние негативных факторов стимулирует выработку аутоантител к мембранам альвеол легких и почечных клубочков. Исследования показали, что в значительной степени на развитие аутоиммунного воспалительного процесса влияет активация Т-лимфоцитов, протеолитических ферментов и свободных радикалов, синтеза таких цитокинов, как интерлейкин-1 и тромбоцитарный фактор роста.
Выделяют злокачественный, умеренный и медленный варианты протекания патологии. Клинические признаки злокачественного варианта заключаются в легочных кровотечениях и острой форме почечной недостаточности. Умеренный и медленный варианты проявляются характерными симптомами поражения легких (кашель, одышка, кровохарканье), субфебрильной температурой, слабостью, похуданием, симптомами почечных патологий (гематурия, отеки конечностей, повышение артериального давления).
Тактика лечения зависит от варианта синдрома Гудпасчера, выраженности симптомов и общего состояния пациента.
При острой форме злокачественного варианта проводится интенсивная терапия:
- искусственная вентиляция легких (ИВЛ);
- ингаляции кислорода;
- переливание крови;
- гемодиализ;
- восполнение утраченной жидкости и нормализация водно-электролитного баланса.
Пациентам также назначается:
- пульс-терапия метилпреднизолоном — пациенту кратковременно вводятся некоторые виды глюкокортикостероидов в повышенных дозах, что способствует уменьшению выработки аутоиммунных антител и частоты развивающихся осложнений;
- комбинированная пульс-терапия — введение больному комбинации кориткостероидных гормональных средств и цитостатических препаратов также оказывает иммуносупрессивный эффект, после возвращения показателей лабораторных и рентгенологических исследований к норме пациент переводится на поддерживающий режим терапии;
- моноклональные антитела — инновационный метод, основанный на способности препаратов присоединяться к экспрессируемому на поверхностной мембране В-лимфоцитов белку CD20 и угнетать их активность, таким образом популяция лимфоцитарных клеток обновляется и останавливается разрушение тканей аутоиммунными антителами;
- плазмаферез — безопасный способ очистки плазмы от циркулирующих иммунных комплексов путем центрифугирования, забранная у пациента кровь помещается в центрифугу, где происходит отделение плазмы от эритроцитарной массы, которая, в комплексе с плазмозаменяющими растворами, вводится обратно в кровоток больного.
- Гемодиализ в Израиле
- Плазмаферез в Израиле
Синдром Гудпасчера
Классической триадой, выражающей клинико-патогенетическую сущность этой болезни, являются легочные кровотечения, гломерулонефрит и антитела к антигенам основной мембраны капилляров легких и почек. Заболевание встречается редко и может поражать любой возраст, но чаще болеют молодые мужчины. Конкретные причины неизвестны; не раз описывалось развитие синдрома Гудпасчера после недавно перенесенного гриппа или вдыхания углеводородов. В связи с этим не исключено, что подобные воздействия таким образом изменяют химическую структуру упомянутых выше антигенов основных мембран, что они приобретают аутоантигенные свойства и вызывают продукцию соответствующих антител с патогенными свойствами.
В тканях почек с помощью иммунофлюоресцентного метода обнаруживают линейные отложения антител к базальным мембранам, сочетающиеся в ряде случаев с отложениями фракции комплемента С3. В то же время при электронномикроскопическом исследовании не обнаруживают отложений иммунных комплексов. Циркулирующие антитела к базальным мембранам канальцев, клубочков и легочных альвеол в сыворотке крови обнаруживают более чем у 90% больных (особенно в ранней стадии заболевания), однако они не отражают тяжести органных изменений или общего прогноза, имея, таким образом, в основном диагностическое значение. Уровень сывороточного комплемента и циркулирующих иммунных комплексов в норме. При гистологическом исследовании почечные клубочки у некоторых больных могут выглядеть нормальными, но в большинстве случаев наблюдается явная патология — от очаговых пролиферативных изменений до некротического гломерулонефрита. Наиболее часто развиваются экстракапиллярные «полулуния». В легких находят кровоизлияния в полость альвеол с картиной альвеолита или без нее.
В начале заболевания клинические проявления связаны прежде всего с поражением легких — кашель, небольшая одышка и особенно кровохарканье; реже наблюдается легкий цианоз. При аускультации возможны влажные хрипы. Рентгенологически характерны инфильтраты разной величины в обоих легких, особенно в прикорневых областях. В мокроте, как правило, обнаруживают макрофаги, содержащие железо. Повышенное отложение железа в легочной ткани может быть установлено сканированием с ^Ре. У многих больных имеют место лихорадка, боль в суставах, резкая общая слабость, но в ряде случаев эти симптомы выражены слабо или отсутствуют. У большинства больных с первых дней или недель заболевания регистрируют признаки гломерулонефрита. В анализах крови обнаруживают повышенную СОЭ и лейкоцитоз; позже в результате легочных кровотечений возможна гипохромная анемия.
Течение болезни в целом неблагоприятное, хотя и неоднотипное. На первых этапах основной угрозой являются легочные геморрагии, причем нередко больной умирает в результате первого и единственного профузного кровотечения. У ряда переживших это кровотечение может развиться относительная ремиссия легочного процесса, но во многих случаях кровохарканье и легочные геморрагии рецидивируют. Поражение почек у отдельных больных остается относительно нетяжелым, но в большинстве случаев быстро прогрессирует с развитием олигурической почечной недостаточности, приводящей к смерти в течение нескольких месяцев и даже недель. Средняя продолжительность жизни у неадекватно леченных больных составляет менее полугода.
Преимущества лечения в Израиле
- Высококвалифицированные специалисты, обладающие огромным опытом лечения редко встречающихся аутоиммунных заболеваний.
- Оснащение медицинских центров современной аппаратурой.
- Точная диагностика с применением современных методик.
- Включение в комплексную лечебную программу прогрессивных методов и новейших лекарственных препаратов.
- Демократичные цены.
Своевременное прохождение лечебного курса позволяет значительно улучшить прогноз и устранить болезненные симптомы. Не теряйте времени, обращайтесь в выбранную клинику и немедленно начинайте лечение.
- 5
- 4
- 3
- 2
- 1
(0 голосов, в среднем: 5 из 5)
Причины
Причины синдрома Гудпасчера:
- причина возникновения синдрома неизвестна, но выявлена непосредственная связь с бактериальной и вирусной инфекциями, а также приемом некоторых препаратов: иммуносупрессивных, противовоспалительных, цитостатиков;
- синдром Гудпасчера может развиться под воздействием химических и физических факторов внешней среды (органические растворители, действие углеводородов, пар лаков, бензина), на фоне онкозаболеваний;
- при систематическом употреблении кокаина также описаны случаи развития данного заболевания;
- ВИЧ-инфекция;
- аутоиммунная причина развития заболевания является наиболее распространенной, при ней происходит выработка антител к определенным структурам легких и почек.
Симптомы
Симптомы синдрома Гудпасчера проявляются в следующем:
- основной признак заболевания – это сочетание симптомов гломерулонефрита с кровохарканьем (признак распада легочной ткани);
- появляются периферические отеки (отеки лица, живота, ног);
- отмечается малокровие (анемия);
- прогрессирующая боль в грудной клетке, кашель, одышка;
- выраженное недомогание, слабость, похудение;
- периодически наблюдается повышение температуры тела;
- воспаление глаз;
- уменьшение объема мочи;
- появление крови в моче;
- артериальное давление повышается от 140/90 мм рт. ст. и выше.
Диагностика
- анализ анамнеза заболевания и жалоб – какие симптомы появились и когда, обращался ли пациент к врачу, как изменялись симптомы со временем, какие обследования и лечения проводились и каковы их результаты;
- анализ анамнеза жизни, при котором уточняются данные о наличии вредных привычек, о хронических заболеваний и о перенесенных ранее заболеваниях;
- анализ семейного анамнеза, при котором уточняется, встречалось ли подобное заболевание у родственников (например, быстропрогрессирующий гломерулонефрит);
- общий анализ крови – позволит обнаружить любые признаки воспалительного процесса в организме (значительное повышение уровня скорости оседания эритроцитов, повышение уровня лейкоцитов, высокое содержание ретикулоцитов);
- биохимический анализ крови – позволит обнаружить повышенный уровень остаточного азота и понижение содержания сывороточного железа;
- анализ мочи, который позволит обнаружить следующие изменения: протеинурию, при которой в моче обнаруживается белок;
- гематурию, при которой в моче обнаруживается кровь;
- цилиндрурию;
- как правило, в осадке моче обнаруживают эритроциты, лейкоциты, эритроцитарные и зернистые цилиндры.
Лечение
В лечение синдрома Гудпасчера входит следующее:
- раннее назначение крупных доз иммуносупрессантов и кортикостероидов;
- плазмаферез – с целью немедленного удаления антител, циркулирующих в крови (это процедура, в ходе которой у пациента берется порция крови, из которой удаляется плазма, а затем кровяные клетки возвращают обратно в сосуды);
- гемодиализ, с помощью которого проходит очищение и фильтрация крови вне организма;
- симптоматическая терапия, которая включает назначение препарата железа и повторные переливания крови.
Осложнения
Если у пациента выявлен синдром Гудпасчера, на сегодняшний день все доступные методы лечения не могут обеспечить полного излечения или предотвращения обострения:
- во многом прогноз синдрома остается крайне неблагоприятным;
- развитие почечной недостаточности в острой форме;
- повторяющиеся легочные кровотечения;
- летальный исход.